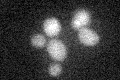
YNR054C
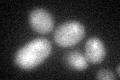
YNR054C
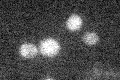
YNR054C

View description
Essential nucleolar protein involved in pre-18S rRNA processing; binds to RNA and stimulates ATPase activity of Dbp8; involved in assembly of the small subunit (SSU) processome
Localization:
Intensity:
Fold change:
Significance:
-
C’ GFP library in SD
below threshold15.93 -
N' NOP1pr-GFP in SD

nucleus,nucleolus117.645 -
N' TEF2pr-mCherry in SD

nucleus,nucleolus12.6557 -
N' NATIVEpr-GFP in SD

nucleolus42.4883 -
N' TEF2pr-VC and Cyto-VN in SD

nucleus,nucleolus55.2216 -
C’ GFP library in SD+DTT
cytosol16.341.02No -
C’ GFP library in SD+H2O2

cytosol17.361.08No -
C’ GFP library in Starvation Media
cytosol16.31.02No -
C’ GFP library on the background of Pup2-DaMP

below threshold -
C’ GFP library on the background of CCT mutant

below threshold16.83051.05594No
